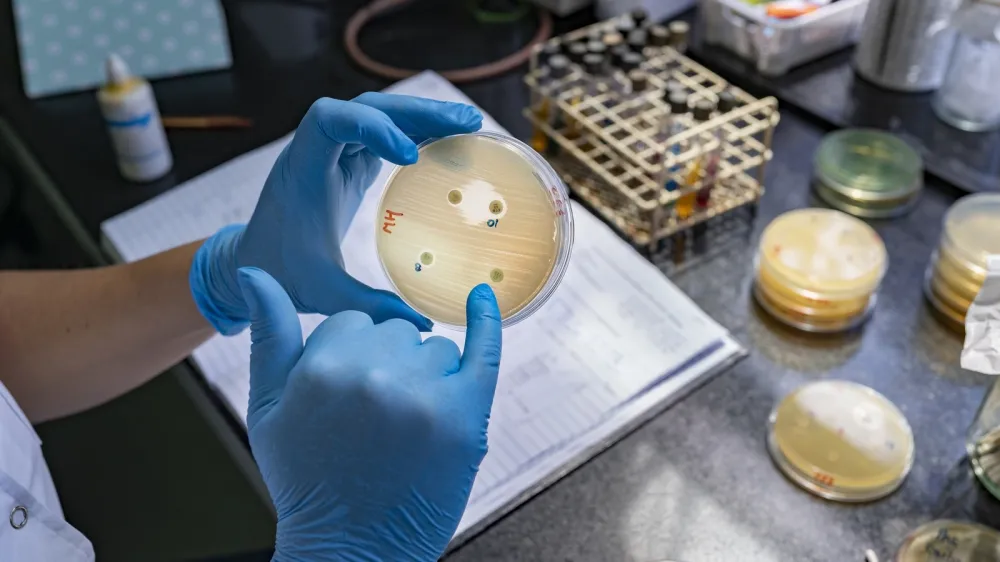
WHONET-Argentina (WHONET-ARG) Antimicrobial Resistance (AMR) Surveillance Network`s coordinator Celeste analyzes phenotypic tests to detect antimicrobial resistance (AMR) mechanisms at Malbrn Institute in Buenos Aires, 10 October 2021. AMR occurs when bacteria, viruses, fungi and parasites change over time and no longer respond to medicines. This makes infections harder to treat and increases the risk of disease spread, severe illness and death. Antimicrobial resistant organisms are found in people, animals, plants and the environment (in water, soil and air). AMR is considered one of the top 10 global public health threats facing humanity. AMR can occur naturally over time, usually through genetic changes. However, misuse and overuse of antimicrobials is a main driver of AMR, as is lack of access to clean water, sanitation and hygiene (WASH) for both humans and animals; poor infection and disease prevention and control in health-care facilities and farms; poor access to quality, affordable medicines, vaccines and diagnostics; lack of awareness and knowledge; and lack of enforcement of legislation. The Servicio Antimicrobianos of the Instituto Nacional de Enfermedades Infecciosas (INEI) is part of the Administracin Nacional de Laboratorios e Institutos de Salud Dr Carlos G. Malbrn (ANLIS-Malbrn, known locally as the Malbrn Institute). The Malbrn Institute is a key space for AMR research, diagnosis, and surveillance, not only for Argentina, but also as a Regional Reference Laboratory for Antimicrobial Resistance for the Pan American Health Organization (PAHO) and as a Collaborating Center on Antimicrobial Resistance Surveillance for PAHO and the World Health Organization (WHO). Malbrns influence on public health is vital in tracking the emergence of and controlling the spread of AMR in Argentina and the region. The institute's multidimensional work is mainly focused on five strategic areas: Reference Diagnosis, AMR Surveillance, External Quality Assessment Programs, Human Resources Training and Applied Research. As part of the reference diagnostic work, microbiology laboratories can request the Malbrn Institute to conduct extensive susceptibility testing and molecular characterization of clinical bacterial isolates to provide alternative treatment options for infected patients.

Nov državni praznik bi sicer ne bil dela prost dan, je dejal Štih in dodal, da bi pa lahko veliko doprinesel k promociji znanosti. K promociji znanosti pa bi lahko prispevalo tudi preimenovanje ene od državnih štipendij, sta razmišljala akademika.
Štih in Forstnerič sta sicer predsednici DZ predstavila najvišjo znanstveno in umetniško ustanovo v Sloveniji, ki združuje najbolj ugledne strokovnjake na različnih področjih znanosti in umetnosti. Sedež akademije je v Ljubljani, letos pa bodo, kot je poudaril predsednik SAZU, praznovali 85. obletnico ustanovitve akademije.
SAZU obravnava aktualno dogajanje v znanosti in umetnosti tudi v okviru delovnih teles. Med trenutno bolj dejavnimi telesi je Štih izpostavil sveta za varovanje okolja in za energetiko ter komisijo za človekove pravice.
Omenil pa je tudi svet za razvoj, katerega področje dela je priprava, koordinacija in organiziranje javnih strokovnih razprav o temeljnih vprašanjih družbenega razvoja, ki imajo dolgoročne pomembne posledice za slovensko družbo. Kot je še dejal Štih, so bili v SAZU zelo dejavni tudi v času epidemije covida-19, ko so sodelovali z različnimi deležniki pri obvladovanju krize in pozivali ljudi k cepljenju.
Klakočar Zupančič je z zanimanjem prisluhnila predstavitvi, pobudam in stališčem akademikom ter izrazila pripravljenost za sodelovanje pri odprtih vprašanjih v skladu s svojimi pristojnostmi, so še dodali iz DZ.